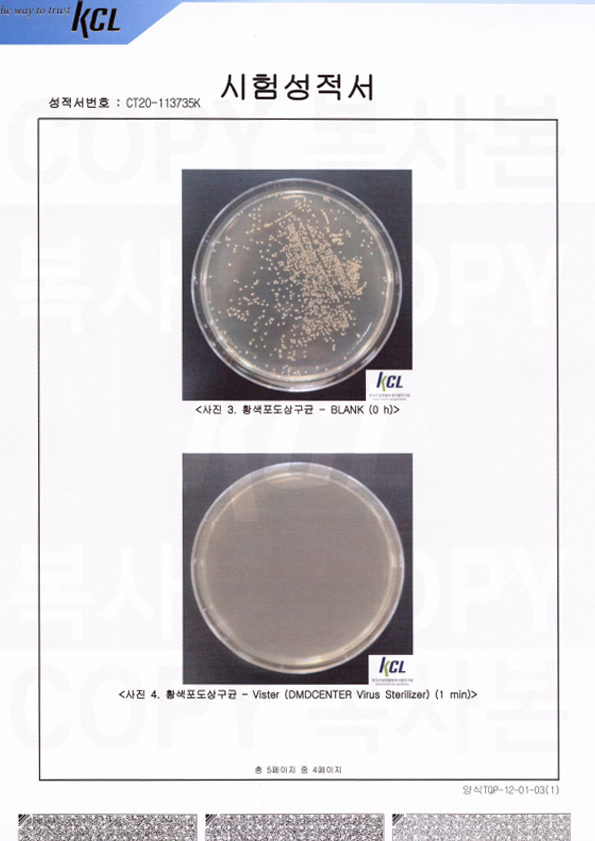

PRODUCT & SERVICE
ASMedi
- TUGU SMART
- ASKO119
- ASMedi
>
제품 및 서비스
>
ASMedi
ASMedi
병원용 음압 공기정화 살균기
(ARDC-2502)
평소에는 공기정화살균기로 비상시에는 음압기로 사용할 수 있는 실내용 음압기 (2020년형 신제품)

음압 공기정화 살균기 (ARDC-2502)
| Model | ARDC-2502 | ||
|---|---|---|---|
| 제품 사양 | 본체 | 공급전원 | AC 220V, 60Hz, 750W |
| 외장재질 | 분체도장강판 | ||
| 풍량(팬) | 최대 70CMM(㎥/min) | ||
| 풍량 (필터 장착) |
최대 26.5CMM(㎥/min) | ||
| 크기 및 중량 | 672*579*1314(mm), 129kg | ||
| UV LED | UV-C (10mW x 48ea) UV-A (450mW x 6ea) |
||
| 운전방식 | 음압기: 0~100 / 디지털 풍량제어 공기정화기: 수동, 자동, 최대, 수면 |
||
| 필터 | Pre, Carbon | 56CMM, 15mmH2O | |
| Medium | 29CMM, 15mmH2O(≥85%) | ||
| HEPA | 26CMM 29.7mmH2O(≥99.99%,0.3㎛) | ||
* 음압기로 사용시 최대 53㎡ (16평) 적용 가능 (-2.5Pa 이상 음압형성, 12ACH, 2.4m 높이 기준)
* 공기정화살균기로 사용시 최대 204.4㎡(62평) 적용 가능.
- ○ 평상시 공기정화살균기로 사용하다가 비상시 음압기로 전환 사용 가능한 신개념 모델 (특허출원)
- ○ 미려한 디자인과 저소음 설계로 음압격리병실에 최적화된 실내용 음압공기정화기
- ○ 2.5m 높이 기준 1~6인 병실 (최대 16평) 까지 질병관리본부 및 미국CDC 음압병실 기준 충족
- ○ 고성능 BLDC 모터 적용으로 수시로 변하는 내외부 환경에 따라 자유로운 출력 조절 가능
- ○ 4단계 고성능 청정필터 시스템 (프리, 미디움, 헤파, 카본) 적용
- - 프리 및 미디움 필터 (굵은 먼지 제거 및 헤파필터 보호)
- - 헤파 필터 (바이러스 비말 등 0.3㎛ 이상 입자를 99.99% 이상 제거)
- - 카본 필터 (VOCs, 냄새 저감)
- ○ 10년 이상 반영구적 사용이 가능한 54개의 고성능 UV LED 적용
- - 특히, 48개의 10mW급 고성능 UV-C LED가 헤파필터 하단에 장착되어 박테리아 및 바이러스를 99.99% 이상 살균
- ○ 온도, 습도, CO2, VOCs, 미세먼지 (PM1.0) 측정 센서를 통한 자동운전
- ○ 2중 필터보호시스템 적용으로 사용자의 돌발행동으로부터 필터 훼손 방지
- ○ 간편한 필터교환 및 누설방지를 위한 고강성 토글 클램프 방식 필터 교환 시스템 (특허출원)